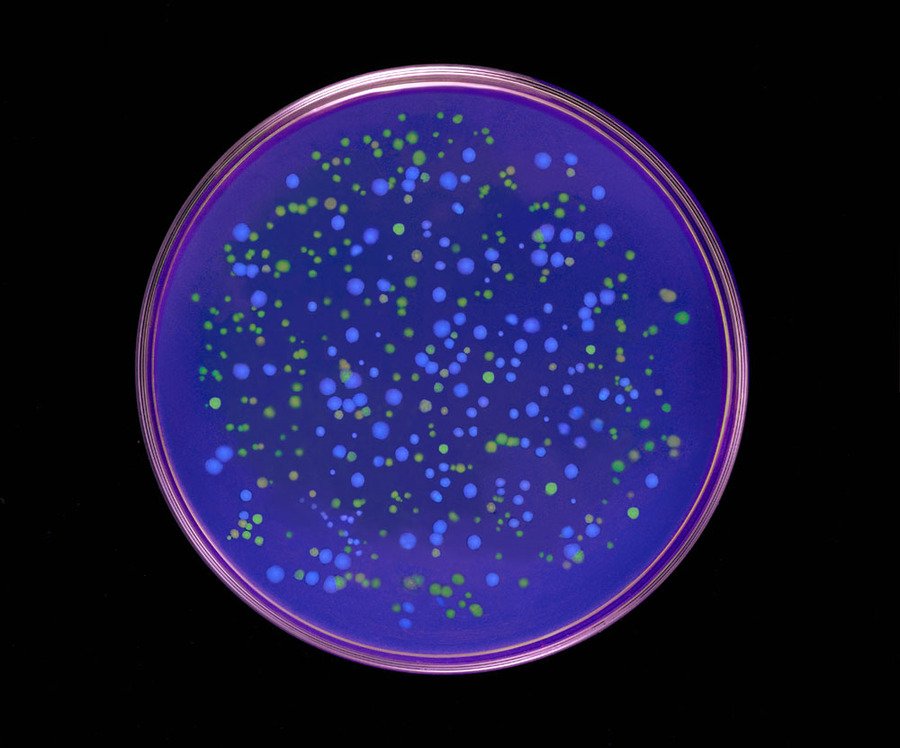
big

Исследователи возводят концепцию новых медиа к разным источникам, отмечая при этом, когда когда-то любое медиа было «новым».
Лев Манович приводит в качестве раннего примера «медиабезумия» ажиотаж вокруг дагерротипов, которые были представлены широкой публике в 1839 году изобретателем Луи Дагером. Новейшая техника репродукции немедленно стала предметом всеобщего интереса. В это же время Чарльз Бэббидж и Ада Лавлейс разрабатывают концепции аналитических вычислительных машин. Манович связывает интерес к механизации анализа данных и к новым медиаустройствам с возросшей необходимостью показывать аудитории культурный контент больше, чаще, быстрее.
Многие исследователи также возводят стратегии новые медиа к стратегиях дадаизма — не напрямую, но с точки зрения того, что и дадаисты, и художники новых медиа реагируют на технический прогресс с критической точки зрения. Интересно, что у дадаистов импульсом к исследованию технологий становится ужас военных действий. Первая Мировая война продемонстрировала тёмную индустриализации, связанную с производством оружия. В попытке осмыслить новые отношения человека и техники дадаисты обратились к миру технологий и воспроизводимых объектов.
По аналогии с ними художники новых медиа в наше время обращаются к теме цифровых технологий. Эпоха дигитализации изменила то, как участники творческого процесса воспринимают мир и себя в нём, а также порождает новые способы взаимодействия с искусством.
Здесь можно вспомнить «Генезис» Эдуардо Каца, проект на стыке искусства и науки. Ключевой элемент работы — так называемый «ген художника». Для его создания Кац перевёл отрывок из библейского Генезиса на азбуку Морзе, а затем на четырёхбуквенный шифр пар ДНК.
«И да владычествует человек над рыбами морскими, и над птицами небесными, и над скотом, и над всею землею, и над всеми гадами, пресмыкающимися по земле»
[Бытие, Глава 1, стих 26]
Выбранные слова отсылают к сомнительной для автора идее господства человека над всей живой природой, а азбука Морзе отсылает к началу эры информационных технологий.
Genesis. Эдуардо Кац. 1999
Ген Творения был добавлен в бактериальную среду в чашке Петри, которая была выставлена в галерее. Посетители, включая и выключая ультрафиолетовый свет, влияли на состояние бактерий в чашке, что вносило изменения в библейский текст. При этом зрители окружены текстуальной составляющей со всех сторон: на стены транслируется вид чашки Петри, похожую на гигантский глаз, и текст из Библии в нескольких версиях, включая коды.
Genesis. Эдуардо Кац. 1999. Валенсийский институт современного искусства
Это подводит нас к актуальной в сегодняшнее время теме отказа от антропоцентричного восприятия. На смену Витрувианскому человеку приходит пост-человек, не полагающий себя центром мира и моделью вселенской гармонии. Он отказывается от поддержания иерархии, где человек должен «владычествовать» над всем миром, и вместо этого воспринимает себя как актора, равного другим человеческим и не-человеческим акторам.
В этом исследовании предлагается проанализировать искусство новых медиа через призму философии постгуманизма. Этот подход обосновывается тем, что среди объектов новых медиа многие предлагают пережить некий трансформативный опыт, вступить в диалог с неочевидным собеседником (от дерева до ИИ) или подвергнуть сомнению аксиомы антропоцентричного мира, что будет рассмотрено впоследствии.
Термин «постгуманизм» впервые возникает в 1977 г. в статье И. Хассана «Прометей как перформер: на пути к постгуманистической культуре». Позиция Хассана заключалась в том, что Прометей как персонаж мифа размывает границы между двумя полярностями бинарной системы, что является основной характеристикой новой эпохи. Субъект и объект, цивилизация и природа, человек и машина — эти категории сливаются, становясь частью более сложной системы, в которой можно обладать множеством идентичностей. Огонь, который Прометей даровал людям, Хассан сравнивает с технологиями, которые изменили мироощущение человека.
«Мы должны понять, что человеческая форма — включая человеческое желание и все его внешние репрезентации — может радикально измениться и, таким образом, должна быть пересмотрена»
[Ихаб Хассан, 1977]
Ключевое отличие постгуманистического подхода от антропоцентрического подхода, который господствовал в западной культуре с Возрождения — сознательный отказ от восприятия человека как центра Вселенной, как самого важного из объектов и как единственного обладателя субъектности.
«Постчеловеческий субъект — это совокупность разнородных компонентов, материально-информационная сущность, границы которой строятся и реконструируются непрерывно»
[Кэтрин Хейлс, 1999]
Человек, который более не ощущает себя человеком в антропоцентрическом смысле, вынужден искать не только новое место в структуре мира, но и новые способы создавать релевантное искусство. Перестав быть мерилом всех вещей, (пост)человек примеряет мир уже не к собственному телу, а к множеству иных тел — это другие люди, растения, живые организмы, машины. Потенциалом к субъектности и чувственности наделяются как биологические, так и технологические и дигитальные объекты. Выходя из бинарной системы, субъект (постчеловек) получает возможность выйти за пределы иерархической структуры, однако также оказывается в пространстве неопределённости.
Выделение в постгуманистической традиции триады «человек-природа-машина» означает нивелирование иерархической системы с человеком на вершине пирамиды.
На примере искусства новых медиа можно увидеть воплощение этих философских концепций не просто как абстрактную идею или как изображение, а как нечто реальное, присутствующее в физическом, или напротив, в мире дигитальном, что в современности уже можно назвать полноценным продолжением реальности.
В пространстве новых медиа все участники триады «человек-природа-машина» могут пройти через трансформации. Образуются новые сущности, идентичности, структуры, существующие на границе физического и цифрового мира. Характеристики одного присваиваются другому и наоборот.
Например, «природное», то есть биологическое или органическое, может превратиться в цифровой архив, как в инсталляции «Pulse Index»: Рафел Лозано-Хеммер собирал отпечатки пальцев и записи сердцебиения посетителей своей выставки и проецировал биометрические данные последних десяти тысяч посетителей на стену галереи. Данные на стене постоянно обновлялись, фиксируя новых и новых посетителей. Это превратило часть галереи в архив, отражающий краткий момент её бытовая в период выставки. База данных, замещающая нарратив, вообще характерная для новых медиа, как отмечает Манович, поскольку она представляет собой новый способ структурирования человеческого опыта.
Pulse Index. Рафел Лозано-Хеммер. 2010. Музей Хиршхорн
С другой стороны, цифровые данные порождают новую среду, которая воспринимается как реальная. Строчки кода превращаются в 3d графику, а в случае таких проектов, как «The Chalkroom» Лори Андерсона или «View of Harbor» Джона Рафмана — в виртуальную реальность. Согласно Дэвиду Чалмерсу, VR — не «осознанная галлюцинация», а полноценная реальность. Как минимум, она может вызвать у зрителя реальные физические ощущения, воздействуя на него не только через видео и аудио, но и через контроллеры или датчики на специальных жилетах, имитирующие тактильные ощущения от ситуаций, переживаемых людьми в виртуальной среде.


The Chalkroom. Лори Андерсон. 2017 / View of Harbor. Джон Рафман. 2018
Что интересно, многие VR-работы включают в себя какое-то освоение реального пространства, хотя для зрителя по сути нужны лишь шлем и контроллеры. Пока зритель смотрит работу и взаимодействует с ней, он тоже становится тем, на кого смотрит другой зритель (тот, кто без шлема), сливаясь с созерцаемым пространством и становясь для другого зрителя практически частью инсталляции.
Эти проекты — пример того, как размываются границы между физическим и виртуальным, органическим и цифровым.
Наша повседневность трансформируется и требует от человека адаптации к новой реальности, и искусство новых медиа откликается на эти перемены, предлагая человеку получить опыт существования в новых типах среды. Это согласуется с постгуманистической позицией, которая предполагает создание новой экосистемы связей между животными, растениями, машинами, людьми, артефактами и другими потенциальными акторами.
Объектом исследования и трансформации становится не только среда. Живое существо тоже становится новым медиа.
Перестройка идеи человека предполагает переосмысление взаимодействия нас с машинами и природой. Согласно Рози Брайдотти, становление постчеловеком можно рассмотреть как синтез нескольких модусов состояния: становление-машиной, становление-животным, становление-землёй. Эти виды отношений трактуются ей как нечто большее, чем метафора: так, zoe-подход предлагает рассмотреть всех живых существ как априори равных в качестве «товара» в рыночной экономике, а современные технологии говорят о возможности слияния человеческого сознания с электронной сетью.
«Разработка новых нормативных структур для постчеловеческого субъекта является основной задачей коллективно запущенных некоммерческих экспериментов с интенсивностью, то есть с тем, чем мы в состоянии стать»
[Рози Брайдотти, 2013]
В искусстве новых медиа трансформация человека, его слияние с машиной или становление не-человеком тоже не метафора, а факт.
Например, художник Нил Харбисон, который официально идентифицирует себя как киборг, имплантировал в голове антенну, преобразующую световые частоты в звук, что позволило ему преобразовывать их в арт-объекты. Однако не менее важно то, что он преобразовал себя в существо, которое не является «человеком» по собственным ощущениям, а также может воспринимать инфракрасные и ультрафиолетовые частоты, недоступные человеческому глазу. А художник-перформер Стелларк, изучающий способы модифицировать тело при помощи протезов, VR-систем и биотехнологий для создания альтернативых способов функционирования тела, решил вырастить на своей руке третье ухо, которые может слышать. Для трансляции звуков Стелларк ходил с наушником в третьем ухе.
Многие философы постгуманизма пишут о возрастающей связи между человеком и техником, о постоянном присутствии в жизни экранов и механизмов, но подобные проекты выводят этот тезис на принципиально новый уровень.


Стелларк / Нил Харбисон
Ещё один био-арт перфоманс, «Да живёт лошадь во мне» Марион Лаваль-Жанте, был направлен на размытие границ между человеком и животным. Художница на протяжении нескольких месяцев вводила себе сыворотку лошадиного иммуноглобулина, которые воздействовали на ее эндокринную и нервную системы. На последнем этапе ей ввели кровь лошади, после чего она встала на протезы лошадиных ног и таким образом перешла в состояние «кентавра», расширив границы своего бытия как постчеловеческого субъекта. Целью эксперимента было попытаться уйти от оппозиции человека и природы и создать из себя синтез человеческого, животного и техногенного.


Да живёт лошадь во мне. Марион Лаваль-Жанте. 2021
«Постчеловеческая субъективность выражает телесно воплощенную, обнаруживающую себя в конкретных обстоятельствах, а следовательно, частичную форму ответственности, основанную на остром чувстве коллективности и реляционности, […], на стремлении к построению сообществ»
[Рози Брайдотти, 2013]
Следующие две работы, «Gaia Hypothesis» Лены Потумерец и «DendroSonic» Андре Свибовича были показаны в галерее «Цифергауз» на выставке «Эволюция». «Gaia Hypothesis» — созданный при помощи компьютерной графики образ живой земли, с которым зритель может взаимодействовать, перемещаясь по залу. Тема работы — технологический прогресс как части эволюции биосистемы. Лена Потумерец создаёт ситуацию невербального диалога человека с цифровой моделью планеты, которая при этом реагирует на действия в физической реальности.
Восприятие этих арт-объектов и других в составе выставки создаёт симфонию сенсорного восприятия, где зритель получает возможность не просто созерцать некое произведение, но и испытать уникальные физические ощущения «от чужого лица», то есть временно разделяя свою идентичность с не-человеческим субъектом.
Gaia Hypothesis. Лена Потумерец. 2024. Галерея «Цифергауз»
«DendroSonic» — исследование звукового, светового и аудиовизуального воздействия на человека в художественном контексте. Работа основана на отсканированных трёхмерных моделях реальных деревьев, записях их звуков и вибрациях, исходящих от растений. Превращая реальный участок леса в цифровую аудиовизуальную среду, Свибович позволяет человеку почувствовать мир так, как его ощущают деревья.
DendroSonic. Андре Свибович. 2024. Галерея «Цифергауз»
Снова возникает уже знакомая нам триада «человек-природа-машина». Арт-объекты оказываются медиаторами между этими участниками невидимого диалога, настраивая на их сближение в рамках постгуманистической экосистемы.
«Entangled Realities», выставка, организованная в Доме электронных искусств в Базеле, полностью посвящена «невидимым связям» окружающим людей. Под связями авторский коллектив понимает как физические пространства, такие как аэропорты и города, так и дигитальные связи и даже генетические связи между людьми. Однако в общую систему выстраиваются не только человеческие агенты, но и не-человеческие, что соотносится с постчеловеческим восприятием мира.
Entangled Realities. Кристиан Хаттер. 2023. Дом электронных искусств
Выставка Recycle Group «New Nature» исследует конкретно тему отношения людей и машин и как личности трансформируются под влиянием современных технологий. Многие работы требуют использования дополненной реальности или виртуальной реальности, что превращает зрителей в участников перфоманса. Взаимоотношения человека и машины выходят на первый план в представлениях о природе и о самих себе. Осмотр выставки через оптику телефона становится моделью современного мира, что подчёркивается отсутствием сопроводительных текстов в физической реальности.
Тотальная инсталляция, заполняющая всё выставочное пространство, акцентирует неизбежность существования в этих условиях.


New Nature. Recycle Group. 2022. Галерея Триумф
Люди оказываются постоянными «собеседниками» экранов и глобальной сети, которая определяет их дальнейшую трансформацию и эволюцию. Человек будущего — уже не витрувианское совершенство, а постчеловеческое существо, глубоко погружённое в дигитальную среду и, если верить постгуманистам, в zoe-среду тоже.
New Nature. Recycle Group. 2022. Галерея Триумф
Выставка «Моей матерью был компьютер», также прошедшая в Цифергаузе», заимствует название из книги постгуманистки Кэтрин Хейлс и посвящена вопросу дихотомии взаимоотношений между человеком и машиной. Все работы созданы при помощи ИИ. Выставка разделена на семь зон — семь стадий принятия от страха к интересу и затем к партнёрству. Выставочное пространство генерирует нарратив, которого не существует в самих работах, и в контексте выставки оказывается не менее важным, как сами экспонаты, которые сами по себе не несут составляющей диалога.
Моей матерью был компьютер. Рендеры экспозиции SA Lab. 2025. Цифергауз
Существование искусственного интеллекта и его проникновение в медиа-среду резко актуализировало множество вопросов, связанных с тем, что такое подлинное творчество, что такое авторство и — самое главное — что такое человек?
Ответ на этот вопрос предполагается найти во время мысленного диалога с нейросетевыми объектами. Человек может противопоставить себя машине, найти какие-то общие черты, попробовать поставить себя в ситуацию, когда ИИ проникает в обычную повседневную жизнь, которую люди привыкли делить только между собой или иными живыми акторами, такими как питомцы.


Марина Купцова. Arbor.Silva. Моей матерью был компьютер. 2025. Цифергауз / Ирина Задорожна. Лимбо ленд. Моей матерью был компьютер. 2025. Цифергауз
Тема искусственного интеллекта присутствует и в работах «Speculative Evolution» Марка Ли и «If AI Were Cephalopod» группы 0(rphan)d (rift>), которые выстраиваются как среда, полностью «обволакивающая» некое пространство и зрителя в нём. Окружённый гигантскими экранами, на которых демонстрируются живые организмы титанических размеров, зритель не может не смотреть на них и при этом не ощущать себя как ещё одного созерцаемого объекта.


Speculative Evolution. Марк Ли. 2024 / If AI Were Cephalopod. 0(rphan)d (rift>). 2019
«Speculative Evolution» отсылает к антиутопическим прогнозам о значительном вымирании живых существ. Автор создаёт модель будущего тридцать лет спустя, где это действительно произошло, но люди заменили вымерших насекомых на сгенерированные при помощи нейросетей и биотехнологий новых существ. Эти новые существа выглядят как пчёлы, улитки и другие вымершие создания, но ведут себя неадекватно, поэтому нуждаются в дальнейших модификациях.
Speculative Evolution. Марк Ли. 2024
Создательницы «If AI Were Cephalopod» проводят аналогию ИИ с осьминогом. Нейросеть метафорически и буквально сливается с фигурой осьминога, превращаясь, видимо, в пост-осьминога. Существо, обладающее вдвойне не-человеческим интеллектом, становится объектом спекуляций и догадок. При этом образ существа призывает расширить понятие «познание» за пределы человеческого разума. В этой ситуации не только зритель познаёт себя и не-человеческое, но и нейро-осьминог тоже познаёт людей.
If AI Were Cephalopod. 0(rphan)d (rift>). 2019
Постгуманистическая перспектива в новых медиа переносит фокус внимания на не-человеческих акторов и в неисследованные или всё ещё не до конца понятные зоны современной жизни. Затрагивая вопросы, связанные с определением понятия «человек», его изменениями в последние десятилетия и потенциальными векторами развития, новые медиа привлекают внимание к трансформациям, через которые мир проходит в настоящее время.
Проекты, выполненные с этой точки зрения, напоминают живые организмы, переменчивые и подвижные. Выбор в пользу таких форм, как цифровое искусство, реплика нейросетевой генерации, био- или сайенс-арт и другие, даёт возможность создать уникальные связи между зрителем, объектом и создателем. Дигитальность, безусловно, остаётся одним из ключевых аспектов создания искусства новых медиа, будь то фиксация процесса в реальности, перенос фрагмента реальности в цифру (или наоборот, перенос цифрового объекта в физическую реальность) или даже создание новой виртуальной реальности с нуля. При этом само современное искусство не сводит восприятие до дигитальности целиком, сохраняя элементы аналоговой формы. В частности, само восприятие искусства новых медиа в реальности можно отнести к этому. Пространство и его организация играют не последнюю роль в восприятии искусства. Даже если архитектура предельно простая, её освоение искусством (рисунками, экранами, проекциями и т. д.) влияет на процесс эмоционального погружения.
Новые медиа, в которых возникают смешиваются специфические формы, такие как видео, саунд и другие, что составляет суть ситуации постмедиа — искусства от постчеловека для постчеловечества.
Лев Манович. Язык новых медиа // М.: АД Маргинем Пресс, 2018. 400 стр.
Рози Брайдотти. Постчеловек // пер. с англ. Д. Хамис, под ред. В. Данилова // М.: Издательство института Гайдара, 2031. 408 стр.
Международная практическая конференция «Медиаискусство — XXI век. Генезис, художественные программы, вопросы образования» / под ред. И. В. Смекалова // РГХПУ им. Строганова, 2023. 591 стр.
Наука телевидения. / под. ред. Г. Р. Консона // Институт кино и телевидения (ГИТР), 2023. 201 стр.
Genesis // KAC [Электронный ресурс]. 2025. https://ekac.org/genesis-info.html (дата обращения: 13.12.2025).
What is New Media Art? // Open Oregon Eduсatonal Resourses [Электронный ресурс]. 2025. https://openoregon.pressbooks.pub/understandingnewmediaarts/chapter/introduction-to-new-media-arts/ (дата обращения: 13.12.2025).
The Art of Virtual Reality // Rob Report [Электронный ресурс]. 2025. https://robbreport.com/shelter/art-collectibles/art-of-virtual-reality-2813207/ (дата обращения: 13.12.2025).
If AI were Cephalopod: 2019 // 0(rphan)d (rift>) archive [Электронный ресурс]. 2025. https://www.orphandriftarchive.com/if-ai/if-ai-were-cephalopod/ (дата обращения: 13.12.2025).
Speculative Evolution // Mark Lee Projects [Электронный ресурс]. 2025. https://marclee.io/en/speculative-evolution/ (дата обращения: 13.12.2025).
Успейте увидеть: в «Цифергаузе» завершается выставка «Моей матерью был компьютер» // Собака [Электронный ресурс]. 2025. https://www.sobaka.ru/entertainment/art/196376?ysclid=mj3adiux45782208951 (дата обращения: 13.12.2025).
Андрей Блохин и Георгий Кузнецов из Recycle Group — о том, чем удивительна выставка New Nature на «Винзаводе» // Umagazine [Электронный ресурс]. 2025. https://umagazine.ru/lifestyle/andrey-blokhin-i-georgiy-kuznetsov-iz-recycle-group-rasskazyvayut-o-vystavke-new-nature-otkrytoy-dlya/ (дата обращения: 13.12.2025).
Entangled realities // Ars Electronica [Электронный ресурс]. 2025. https://ars.electronica.art/newdigitaldeal/de/entangled-realities/ (дата обращения: 13.12.2025).
«Эволюция» взаимоотношений человека и природы глазами медиахудожников // Del’Arte [Электронный ресурс]. 2025. https://delartemagazine.com/tech/evolyuciya-vzaimootnoshenij-cheloveka-i-prirody-glazami-mediaxudozhnikov/?ysclid=mj39bhaby6934791389 (дата обращения: 13.12.2025).